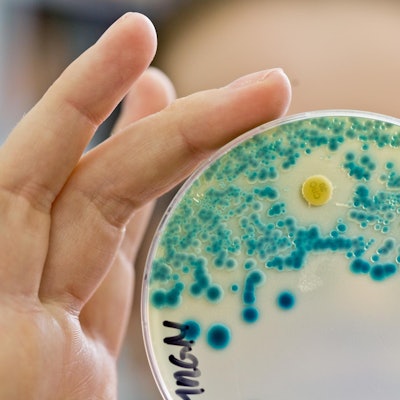
Neuer Inhalt

Beim Schwimmen infiziertZehnjährige stirbt durch hirnfressende Amöbe

In Texas kämpft die zehnjährige Lily auf der Intensivstation um ihr Leben (Symbolbild).
Copyright: Lino Mirgeler/dpa
Whitney – Die zehnjährige Lily Avant stirbt nach einer Infektion, die durch eine Amöbe verursacht wurde. Das gab ihre Cousine Wendy Scott auf Facebook am 16. September bekannt.
Fast täglich war Lily Avant im Brazo River in Texas schwimmen. Nie ist dem Mädchen etwas passiert, schilderte ihre Cousine Wendy Scott gegenüber „Boston 25 News“. Doch im Wasser hatte sich das Mädchen im Wasser mit einer hirnfressenden Amöbe infiziert und ist an der Krankheit gestorben.
Das zehn Jahre alte Mädchen aus Whitney klagte nach einem Ausflug zum Lake Whitney am Labor Day über Kopfschmerzen und Fieber. Ob das Mädchen sich im Fluss oder im See mit der gefährlichen Amöbe infiziert hatte, ist laut dem TV-Sender „KWTX10“ unklar. Das Mädchen lag im Krankenhaus und ist an der tödlichen Krankheit gestorben. Die Krankheit verläuft fast immer tödlich.
Bisher haben nur vier Menschen in den USA die Infektion überlebt
Die Todesrate bei dieser Krankheit liegt bei 97 Prozent. Bisher haben in den USA nur vier Menschen überlebt, die sich mit der Amöbe „Naegleria fowleri“ infiziert haben. Insgesamt sind 143 Fälle zwischen 1962 bis 2016 dokumentiert, heißt es beim Texas Health and Human Service.
Unter dem Hashtag „#5tosurvive“ bat die Familie um Gebete für Lily. Der Hashtag stand dafür, dass Lily Avant die fünfte Person in den USA gewesen wäre, die die Krankheit überlebt hätte. In der Facebookgruppe „#Lilystrong“ berichtete die Familie über den Gesundheitszustand des Mädchens. Die Ärzte hielten die Symptome zunächst für eine virale Infektion und behandelten das Mädchen mit Ibuprofen. Als sich ihr Zustand weiter verschlechterte, brachten ihre Eltern sie in die Notaufnahme und die Ärzte behandelten Lily wegen einer Hirnhautentzündung, schrieb ihre Cousine Wendy Scott auf Facebook.
„Naegleria fowleri“ gelangt über die Nase ins Gehirn
Nach Angaben der US-Gesundheitsbehörde CDC ist „Naegleria fowleri” ein Einzeller. Er kommt im frischen, warmen Süßwasser wie Flüssen, Seen oder heißen Quellen vor. Betroffene infizieren sich in der Regel mit der Amöbe, wenn beim Baden oder Tauchen kontaminiertes Wasser in die Nase gelangt. Die Amöbe kann von dort aus in das Gehirn wandern und eine lebensgefährliche Entzündung von Hirnhäuten und Gehirn auslösen.
Durch verschlucken des Wassers oder auch durch Trinken kann man sich nach Angaben der CDC nicht anstecken. Symptome treten nach einem bis neun Tagen nach der Infektion mit der Amöbe auf. Zuerst bekommen Betroffene Kopfschmerzen, Fieber oder müssen sich auch übergeben. Später können auch ein steifer Nacken, Verwirrtheit, Schwindel und Halluzinationen, Gleichgewichtsstörungen hinzukommen, bis die Betroffenen das Bewusstsein verlieren.
Lily Avant wurde im Cooks Kinderkrankenhaus behandelt
Lily Avant wurde im Cooks Kinderkrankenhaus in Fort Worth behandelt, wie „KWTX 10“ berichtete. Die Ärzte hatten das Mädchen in ein künstliches Koma versetzt. „Sie ist eine Kämpferin. Sie ist stärker als jeder andere, den ich kenne“, sagte ihr Vater John Crawson gegenüber „NBCDFW5“. Er bedankte sich für die große Unterstützung. Jeremy Lewis, der selbst seinen Sohn Kyle durch die Amöben-Infektion verlor, hat eine Organisation gegründet, um dafür zu sorgen, dass mehr Krankenhäuser über ein Medikament verfügen mit dem man Betroffene behandelt kann. Im Cooks Kinderkrankenhaus gibt es das Medikament mit dem Wirkstoff Miltefonsin.
Die Gesundheitsbehörde CDC empfiehlt diesen Wirkstoff. In Laborversuchen hat Miltefonsin den Einzeller abgetötet. Das Medikament wird normalerweise für die Behandlung von Brustkrebs und Leishmaniose genutzt.
Zehnjährige wurde mit dem Wirkstoff Miltefonsin behandelt
In den USA sind Fälle dokumentiert, die eine Infektion mit „Naegleria fowleri” durch die Gabe des Medikaments überlebt haben. Die Chancen diese Krankheit zu überleben sind sehr gering, trotzdem könnte eine frühe Diagnose und Behandlung dazu beitragen, dass Infizierte überleben, heißt es bei der CDC. Die Symptome der Krankheit sind schwer zu erkennen, weil sie einer bakteriellen Hirnhautentzündung ähneln. Deshalb wird die Infektion oft erst nach dem Tod nachgewiesen.
Das könnte Sie auch interessieren:
Sich vor der sehr seltenen Infektion mit der Amöbe zu schützen ist schwierig. Laut der US-Gesundheitsbehörde CDC könnten Menschen das Risiko sich durch den Einzeller zu infizieren verringern, wenn sie beim Schwimmen darauf achten, dass möglichst wenig Wasser in die Nase kommt. (rha)